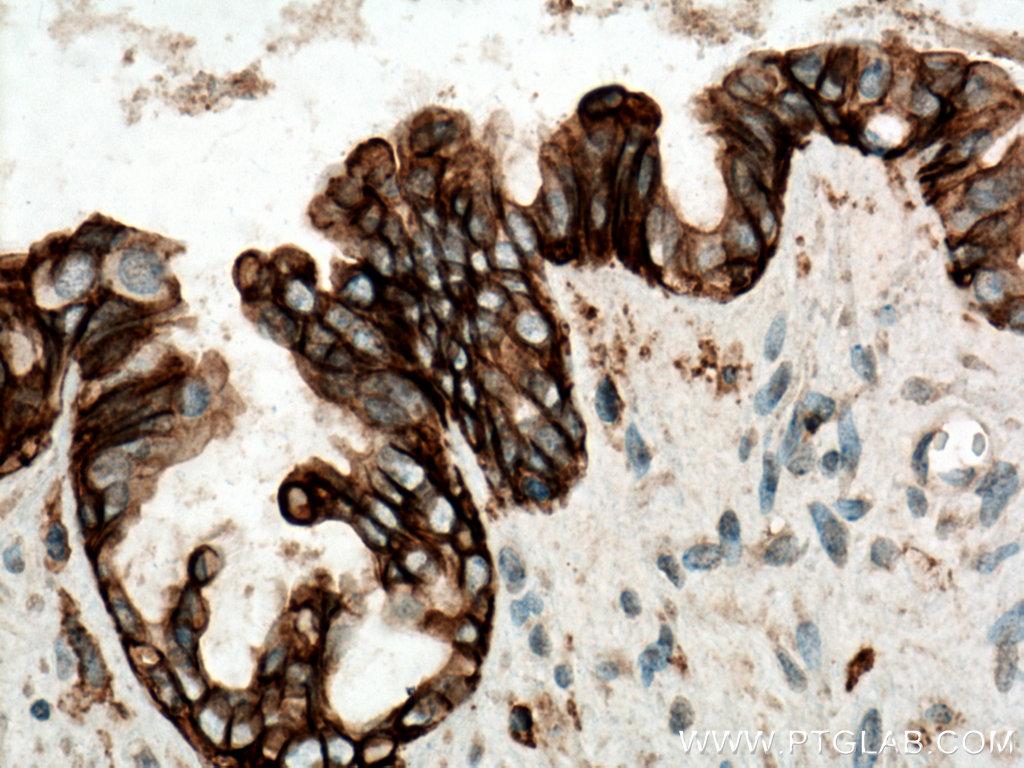
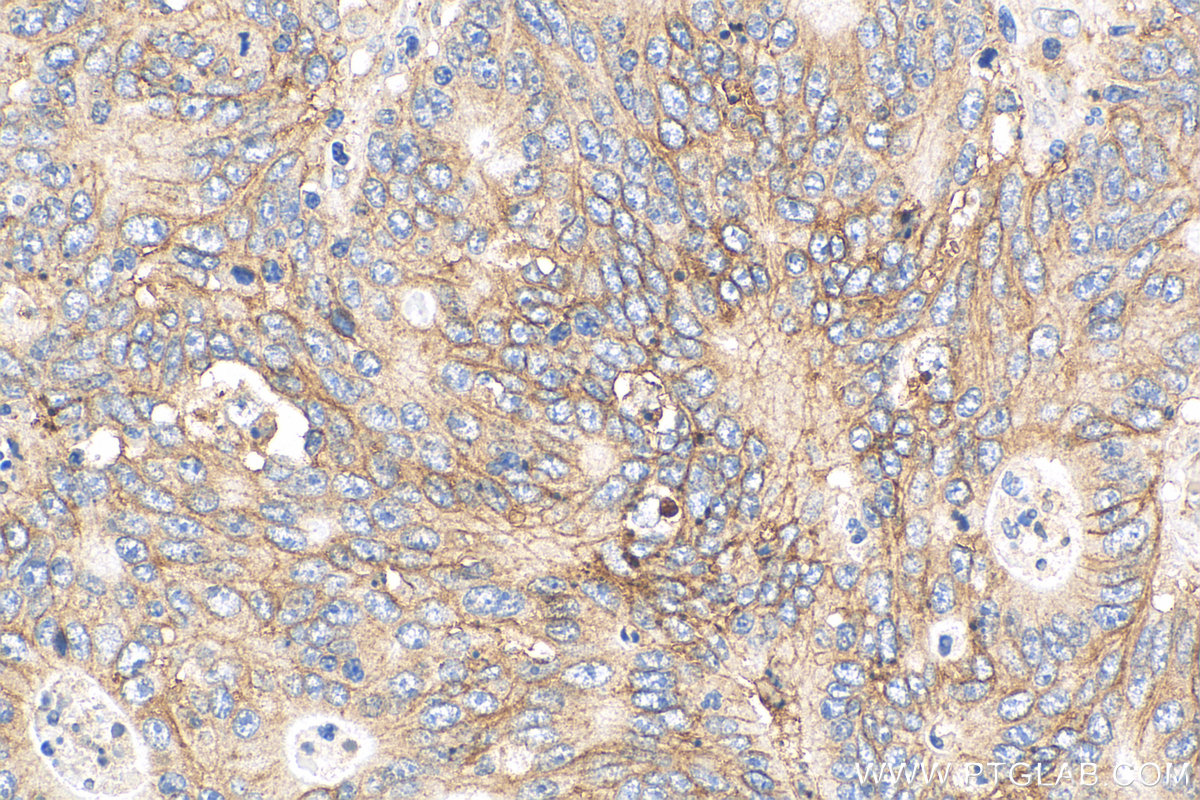

验证数据展示
经过测试的应用
| Positive WB detected in | A431 cells, HeLa cells |
| Positive IHC detected in | human ovary tumor tissue, human breast cancer tissue, human colon cancer tissue, human tonsillitis tissue Note: suggested antigen retrieval with TE buffer pH 9.0; (*) Alternatively, antigen retrieval may be performed with citrate buffer pH 6.0 |
| Positive IF-P detected in | human breast cancer tissue, human ovary tumor tissue, human lung cancer tissue |
| Positive IF/ICC detected in | MCF-7 cells |
推荐稀释比
| 应用 | 推荐稀释比 |
|---|---|
| Western Blot (WB) | WB : 1:5000-1:50000 |
| Immunohistochemistry (IHC) | IHC : 1:1000-1:4000 |
| Immunofluorescence (IF)-P | IF-P : 1:200-1:800 |
| Immunofluorescence (IF)/ICC | IF/ICC : 1:400-1:1600 |
| It is recommended that this reagent should be titrated in each testing system to obtain optimal results. | |
| Sample-dependent, Check data in validation data gallery. | |
产品信息
60232-1-Ig targets CD9 in WB, IHC, IF/ICC, IF-P, ELISA, PLA applications and shows reactivity with human samples.
| 经测试应用 | WB, IHC, IF/ICC, IF-P, ELISA Application Description |
| 文献引用应用 | WB, IHC, IF, PLA |
| 经测试反应性 | human |
| 文献引用反应性 | human, rabbit |
| 免疫原 |
CatNo: Ag14529 Product name: Recombinant human CD9 protein Source: e coli.-derived, PET28a Tag: 6*His Domain: 100-208 aa of BC011988 Sequence: FAIEIAAAIWGYSHKDEVIKEVQEFYKDTYNKLKTKDEPQRETLKAIHYALNCCGLAGGVEQFISDICPKKDVLETFTVKSCPDAIKEVFDNKFHIIGAVGIGIAVVMI 种属同源性预测 |
| 宿主/亚型 | Mouse / IgG1 |
| 抗体类别 | Monoclonal |
| 产品类型 | Antibody |
| 全称 | CD9 molecule |
| 别名 | CD9 antigen, BTCC 1, BA2, 5H9 antigen, 5H9 |
| 计算分子量 | 228 aa, 25 kDa |
| 观测分子量 | 23-27 kDa |
| GenBank蛋白编号 | BC011988 |
| 基因名称 | CD9 |
| Gene ID (NCBI) | 928 |
| RRID | AB_11232215 |
| 偶联类型 | Unconjugated |
| 形式 | Liquid |
| 纯化方式 | Protein G purification |
| UNIPROT ID | P21926 |
| 储存缓冲液 | PBS with 0.02% sodium azide and 50% glycerol, pH 7.3. |
| 储存条件 | Store at -20°C. Stable for one year after shipment. Aliquoting is unnecessary for -20oC storage. |
背景介绍
The cell-surface molecule CD9, a member of the transmembrane-4 superfamily, interacts with the integrin family and other membrane proteins, and is postulated to participate in cell migration and adhesion. Expression of CD9 enhances membrane fusion between muscle cells and promotes viral infection in some cells (PMID:10459022). It is often used as a mesenchymal stem cell marker (PMID:18005405). CD9 is also known as the p24 antigen besides MIC3, TSPAN29 because it is a protein of molecular weight 24 kD. The CD9 antigen appears to be a 227-amino acid molecule with 4 hydrophobic domains and 1 N-glycosylation site.
实验方案
| Product Specific Protocols | |
|---|---|
| IF protocol for CD9 antibody 60232-1-Ig | Download protocol |
| IHC protocol for CD9 antibody 60232-1-Ig | Download protocol |
| WB protocol for CD9 antibody 60232-1-Ig | Download protocol |
| Standard Protocols | |
|---|---|
| Click here to view our Standard Protocols |
发表文章
| Species | Application | Title |
|---|---|---|
Nat Commun A functionally tunable magnetic nanochains platform for N-glycoproteomic analysis of extracellular vesicles from ultratrace biofluids | ||
Transl Neurodegener Abnormal α-synuclein binds to synaptotagmin 13, impairing extracellular vesicle release in synucleinopathies | ||
J Extracell Vesicles 124I-labelled BMSC-Derived Extracellular Vesicles Deliver CRISPR/Cas9 Ribonucleoproteins With a GFP-Reporter System to Inhibit Osteosarcoma Proliferation and Metastasis | ||
Adv Sci (Weinh) Cancer Cell-Derived Large Extracellular Vesicles Promote Venous Thromboembolism by Activating NETosis Through Delivering CYBA | ||
Adv Sci (Weinh) POSTN-Mediated Interplay of M1 Polarized Macrophage with Tendon-Derived Stem Cells to Drive Traumatic Heterotopic Ossification Formation through PTK7/ATK Signaling |